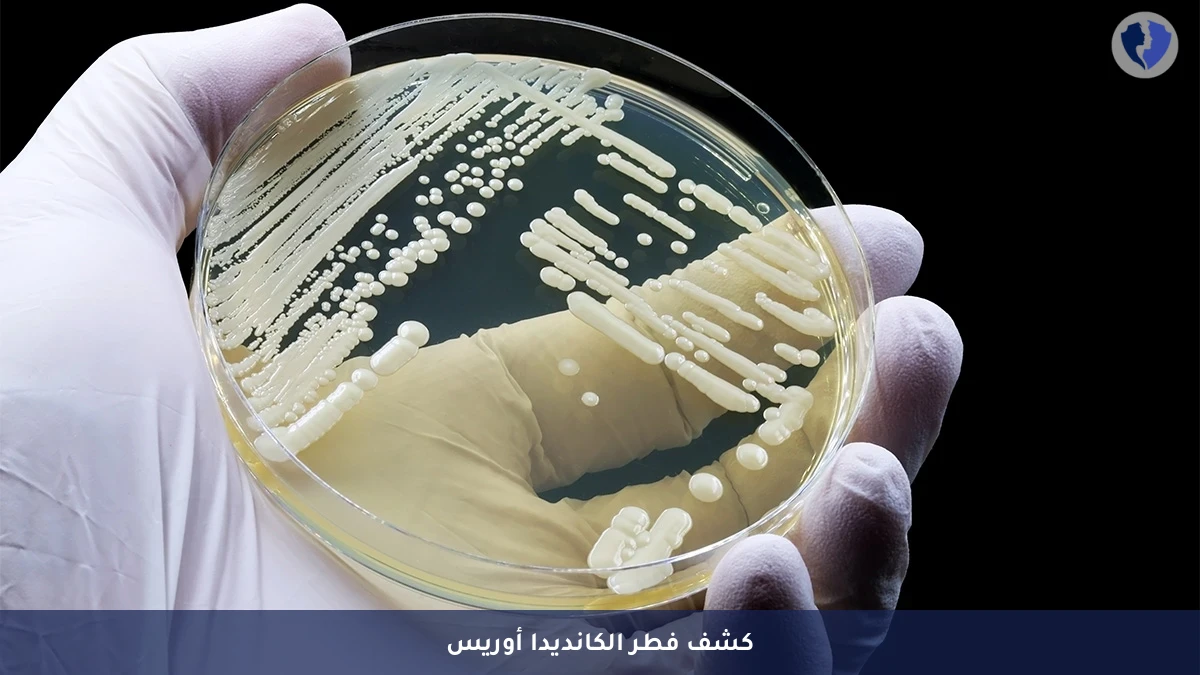
فحص فطر الكانديدا أوريس - مزرعة فطريات للتعرف على فطر الكانديدا أوريس (C. Auris)

تفاصيل الخدمة
فحص فطر الكانديدا أوريس - مزرعة فطريات للتعرف على فطر الكانديدا أوريس (C. Auris)
يتم في هذا التحليل زراعة عينة سريرية (من الدم، البول، الجروح، المسحات التنفسية، أو غيرها) على أوساط زرعية خاصة للفطريات، ثم عزل المستعمرات المشتبه بها. تُستخدم تقنيات كيميائية حيوية متقدمة (مثل قياس الكتلة MALDI-TOF MS) و/أو جزيئية (PCR) لتحديد هوية الفطر بدقة على مستوى النوع، مع التركيز على تمييز Candida auris عن غيره من أنواع المبيضات. يتضمن التحليل أيضاً اختتبار الحساسية للمضادات الفطرية (Antifungal Susceptibility Testing) لتحديد مدى مقاومته للأدوية.